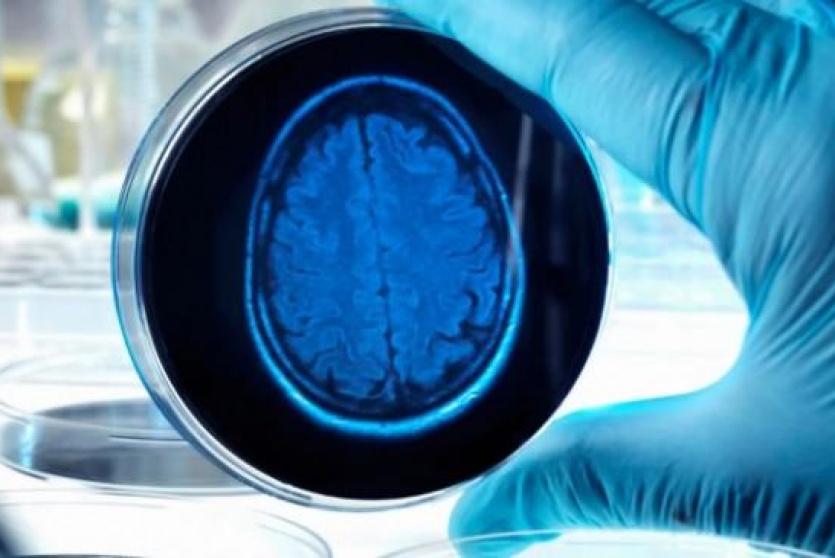

"خطوة تاريخية".. الكشف عن عقار واعد لعلاج مرض الزهايمر
وصف باحثون أجروا تجارب سريرية على عقار جديد لمحاربة مرض الزهايمر، الموافقة على هذا الدواء الذي يبطئ من تطور المرض بأنه "خطوة تاريخية".
ثقافة وفنشاب ويعاني من أعراض الزهايمر.. ممثل شهير يعتزل!
جاء هذا الإنجاز بعد عقود من المحاولات الفاشلة، وأدى إلى أمل بين الخبراء بأن يمهد الطريق أمام علاجات يمكن أن تؤدى في النهاية إلى الشفاء من هذا الذي يعتبر من أهم مشاكل الصحة العامة، إذ يصيب أكثر من 40 مليون شخص في كل أنحاء العالم.
عقار "ليكانيماب"
وجاءت التجارب السريرية لعقار "ليكانيماب" المطور عبر شركتين أميركية ويابانية مشجعة للباحثين.
كما أظهر هذا الدواء قدرته على الحد من تراجع المهارات العقلية العامة لمرضى الزهايمر بنسبة 27% على مدار 18 شهرا - وهي نتيجة متواضعة، ولكنها مهمة، وفق صحيفة "الغارديان" البريطانية.
وعقار "ليكانيماب" هو علاج بالأجسام المضادة يزيل كتل البروتين "بيتا أميلويد" والتي تتراكم في الدماغ.
الدواء الأول
من جانبه، قال مدير معهد أبحاث الخرف في كلية لندن الجامعية، بارت دي ستروبر، "هذا هو الدواء الأول الذي يوفر خيارًا علاجيًا حقيقيًا لمرضى الزهايمر".
كما أضاف ستروبر أنه "بينما تبدو الفوائد السريرية محدودة نوعًا ما، فمن المتوقع أن تصبح أكثر وضوحًا بمرور الوقت".
ونشرت نتائج التجارب السريرية التي شملت 1800 مريض، بالمجلة الطبية "نيو إنغلاند جورنال أوف ميديسين".
كما وجد العلماء أن ليكانماب، عندما يتم تعاطيه بالتنقيط فى الوريد كل أسبوعين، يبطئ من تدهور الذاكرة بنسبة 27% على مدار 18 شهرا.
بدوره، قال أستاذ علم الأعصاب السريري مدير مركز أبحاث الخرف بجامعة كاليفورنيا في لوس أنجلوس، نيك فوكس، "أعتقد أنه يؤكد حقبة جديدة لمرض الزهايمر". وأشار إلى أن هذه الحقبة تأتي بعد 20 عاما من العمل الجاد على العلاجات المناعية المضادة للأميلويد من قبل العلماء.
إلى ذلك، فمن المتوقع أن تؤدي النتائج الإيجابية لهذا العقار إلى جيل جديد من الأدوية التي توفر سيطرة أفضل على مرض الزهايمر.
وقال الدكتور ريتشارد أوكلي، من جمعية الزهايمر بالمملكة المتحدة إن النتائج يمكن أن "تغير اللعبة".
كما تابع: "لا يزال هناك طريق طويل لنقطعه قبل أن نتمكن من رؤية ليكانيماب متاحا ... يجب ألا ننسى أنه لا يمكن إعطاء ليكانيماب إلا للأشخاص المصابين بمرض الزهايمر المبكر والذين لديهم أميلويد في دماغهم، وهذا يعني أن الأشخاص المصابين بأنواع أخرى من الخرف، أو في المراحل المتأخرة من مرض الزهايمر، لا يمكنهم الاستفادة من هذا الدواء".
تأتي هذه النتيجة بعد عقود من الفشل في هذا المجال وشجعت الخبراء على القول إن مرض الزهايمر - الذي يصيب 30 مليون شخص في جميع أنحاء العالم - يمكن علاجه.
وكان دواء آخر توصلت إليه شركة "بايوجين" سمّي Aduhelm ويستهدف أيضاً لويحات الأميلويد، أثار الكثير من الآمال عام 2021 من خلال كونه أول دواء معتمد في الولايات المتحدة ضد المرض منذ عام 2003.
لكنه تسبب أيضاً في جدل، إذ عارضت وكالة الأدوية الأميركية رأي لجنة خبراء اعتبروا أن العلاج لم يثبت فاعليته بشكل كافٍ خلال التجارب السريرية. وقيّدت الوكالة في وقت لاحق استخدامه، حاصرة إياه بالأشخاص الذين يعانون حالات خفيفة من المرض.